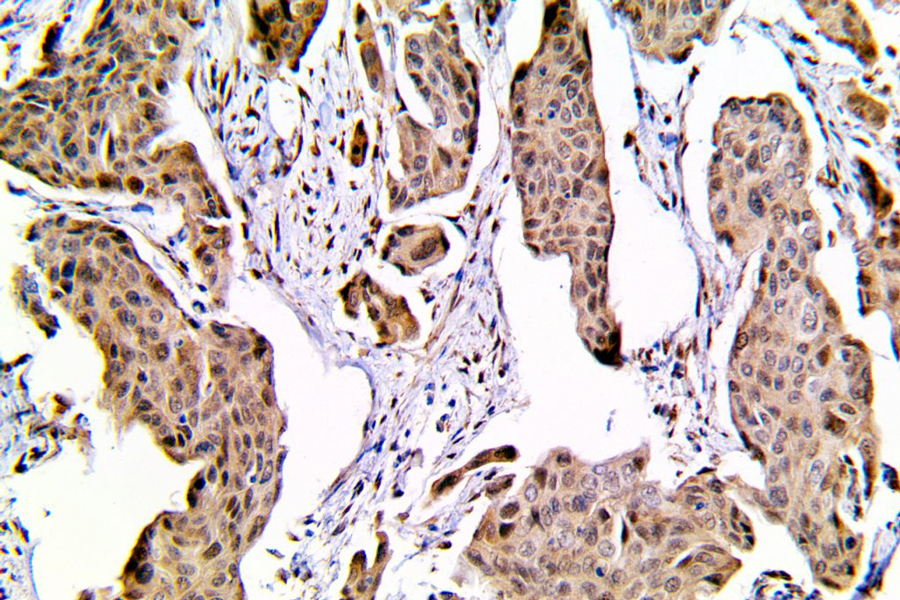

Команда отметила, что патогенез кожных заболеваний до конца не изучен, а методы лечения не оптимальны. Поэтому в своем обзоре они обобщили последние открытия о роли YAP в кожных заболеваниях, современные методы лечения, нацеленные на YAP, и потенциальные возможности для новых методов лечения.
Белок YAP (Yes-associated protein) представляет собой коактиватор транскрипции, который играет роль в регуляции транскрипции генов и передачи сигнала.
Авторы отметили, что аномальная экспрессия белка вовлечена в возникновение и развитие дерматоза. YAP регулирует клеточный гомеостаз, пролиферацию, дифференцировку, апоптоз, ангиопоэз и эпителиально-мезенхимальный переход. Кроме того, он служит потенциальной мишенью во многих биологических процессах лечения дерматоза.
Эффекты YAP на кожу сложны и требуют многомерных подходов к исследованию. YAP функционирует как онкобелок, который может способствовать возникновению и развитию рака, но в настоящее время имеется ограниченная информация о терапевтическом потенциале ингибирования YAP для лечения рака. Также необходимы дополнительные исследования для выяснения роли YAP в развитии и созревании дермальных фибробластов.
Дерматоз – общий термин для обозначения заболеваний кожи и кожных придатков, включая склеродермию, псориаз, буллезную болезнь, атопический дерматит, базально-клеточную карциному, плоскоклеточную карциному и меланому.
Обзор опубликован в журнале Skin Research and Technologies.